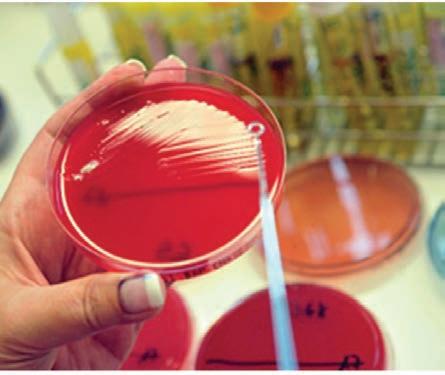

CIP – Каталогизација у публикацији Народна библиотека Србије, Београд
37.016:57/59(075.3)
ТРИФУНОВИЋ, Снежана, 1956Биологија : за 1. разред гимназије / Снежана Трифуновић, Анита Лазаревић, Драгана Цветковић ; [илустрације Ивона Крижак, Марко Јевремовић, Снежана Трифуновић]. - 4. прештампано изд. - Београд : Завод за уџбенике, 2025 (Београд : Бирограф). - 235 стр. : илустр. ; 27 cm Тираж 2.200. - Речник појмова: стр. 224-230. - Библиографија: стр. 231-233.
ISBN 978-86-17-21327-3
1. Лазаревић, Анита, 1962- [autor] 2. Цветковић, Драгана, 1961- [autor]
COBISS.SR-ID 170511369
ISBN 978-86-17-21327-3
плану и програму.
Текст
1. Биологија као природна наука,
2. Особине живих бића,
3. Биолошки макромолекули,
4. Ћелија – грађа и функција,
5. Ћелијска деоба и ћелијски циклус,
6. Филогенија и принципи класификације.




Кључне
•
•
•
•
•
•
•



за многе друштвене науке биологија представља извор основних научних информација. Тако су за области педагогије, психологије и андрагогије не
опходна знања из генетике, физиологије, биологије развића. На основу нивоа проучавања, то јест на основу величине онога што је
предмет проучавања, биологија је подељена на основне дисциплине. То су:
а) молекуларна биологија и биохемија, које проучавају жива бића на
молекулском нивоу; б) ћелијска биологија, која проучава ћелијски ниво;
в) хистологија, анатомија, морфологија и физиологија − проучавају
ткива, органе, органске системе и организме; г) биологија развића и генетика, које се
настанком, развићем и растом организама; д) систематика − проучава разноврсност организама


Укратко

2
1. систематично посматрање, запажање и описивање природних појава;
2. формулисање истраживачког питања;
3. постављање хипотезе;
4. провера хипотезе (експериментом, систематичним прикупљањем великог броја података, мерењем и др.);
5. анализа резултата добијених експерименталном провером
вођење закључка;
6. објављивање резултата у научним круговима



Будући да су познати закони осмозе (вода се креће
у средину
с већом концентрацијом), хипоте
за би могла да се формулише на
следећи начин: за бубрење семе
на неопходно је да количина воде
у земљишту буде већа него у семе
ну, како би семе упијало воду.
Зна се да на клијање семена
утичу и други фактори спољашње
средине, као што су температура, светлост, кисеоник и особи
не земљишта (нпр. концентрација соли). У контролисаном експери
менту мења се количина воде у земљишту, док се остали фактори одржавају константним. Дакле, мењамо количину воде и меримо клијавост семена док темпера
тура, светлост, кисеоник и соли у
земљишту одржавамо константним. Тако долазимо





































домаћих животиња, коришћење микроорганизама за производњу хране (нпр. сира, јогурта) и пића (нпр. пива, вина) и др. Савремена, молекулар
на биотехнологија заснива се на техникама генетичког инжењеринга који
ма се стварају ,,биолошке фабрике” (нпр. овце чије млеко садржи протеине за лечење болести људи), преносе гени из једног организма у други (ГМО) и др.
Молекуларна биотехнологија је значајна за производњу хране, различите врсте индустрије (добијање енергије и сировина), решавање
и др.), у научним истраживањима, као
другим областима људске делатности.

вакцина,
пестициди и сл.
Молекуларна биотехнологија нуди велике


Заокружите
Примењеним наукама припадају:
а) медицина и биологија,
б) фармација и медицина,
в) пољопривреда и хемија,
г) ветерина и биологија,
д) биологија и хемија.
Заокружите слово испред тачне тврдње.
Научници који су изумели електронски микроскоп су:
а) Макс Кнол и Ернс Руска,
б) Хук и Левенхук, в) Матијас




околину.



Систем је, на пример, атом, молекул, ћелија, популација,
а системи су и различите машине. Више информација пронађите на следећим сајтовима: http://www.dr-ralf-wagner.de/Bilder/ Volvox-aureus-DF.jpg и https://www.nasa.gov/image-feature/goddard/hubblelooks-at-leda-89996.
Сваки систем поседује: 1) елементе, 2) везе између елемената и 3) границу.
Додатни текст
Реч универзум
води порекло из
латинског језика (universum од
unus (један) + versus (окренут, наспрам)) и значи: све ствари, као целина, претворене или комбиноване
у једно. У астрономији означава јединство свеукупне материје, енергије
и простора.
другог система. На пример, моле
кују од појединачних својстава
водоника и кисеоника. Молекули
H2O међусобно се повезују и дају
воду, која има својства различита
од појединачног молекула H2O.
У односу на састав, систем
може бити хомоген и хетероген.
Хомоген систем у свим дело
вима има исте особине или се те особине континуирано (равномерно, без прекида)



системи
Живи системи су
већања неуређености околине.
своју уређеност на рачун по
Живи систем је отворен, самоорганизован изотермални систем биомолекула. У њему су сви процеси прецизно повезани и регулисани ензимима (биокатализаторима), које сам синтетише. Живи систем је „хемијска машина” која, процесима циклуса енергије, „извлачи”, претвара и складишти део слободне енергије хемијских реакција.
Живи систем поседује наследни материјал, који се умножава и преноси

систем складишти (депонује) енергију
Сам ток енергије у живом систему не би имао смисао ако се део енер
гије не би сачувао. У живим системима слободна енергија (ΔG), ослобође
на из хемијских реакција, користи се за биосинтезу аденозинтрифосфа
та (ATPa), који је основни енергетски биомолекул. Живи
систем, по потреби, разграђује ATP, а ослобођену хемијску
енергију користи за све врсте рада: за синтезу биомолекула, за механички рад, за транспорт кроз мембрану итд. При томе ATP се разграђује на ADP и Pi (неоргански фосфат), који поново улазе процесе биосинтезе ATPa. Живи систем
они сами прецизно умножавају

система до данас се развило мноштво организама. У сагледавању
Атом се састоји од позитивно
наелектрисаног језгра

једро митохондрије хлоропласти Голџијев апарат
нуклеинске киселине протеини полисахариди липиди нуклеотиди амино-киселине моносахариди масне киселине + глицерол
пируват оксалат цитрат малат изоцитрат
низми који имају еукариотски тип ћелије могу бити једноћелијски или ви
шећелијски, а то су сви остали организми.
Прокариотска ћелија истовремено је и организам. Прокариотски
организми су најсличнији првобитним живим системима. Микроскопске су величине – нису видљиви голим оком. Њихова основна одлика је да
немају једро, а наследни материјал, у виду циркуларне ДНК, налази се у цитоплазми. Размножавају се једноставном деобом (бинарном фисијом).
Неки прокариоти могу да живе и без присуства кисеоника (анаеробни организми).
Еукариотска ћелија може бити самосталан, једноћелијски орга
низам, а у вишећелијским организмима представља јединицу грађе и функције. Еукариотска ћелија је много
може бити веома различитих облика и
организована у структуре које нази
вамо хромозоми. У процесу размно
жавања ћелије еукариота
еукариота је деоба ћелије, док је код вишећелијских




Пример

МЕТАБОЛИЗАМ
Организми су сложени, отворени, изотермални, самоорганизовани и са
назива се метаболизам
Циклус енергије повезује све процесе метаболизма, а чине га биохемијски
процеси добијања хемијске енергије у облику ATPа. У метаболичким
зма и анаболизма – амфиболизам. Управо повезаност свих ових процеса, катаболичких, анаболичких и амфиболичких, чини метаболи
зам.
Исхрана
Метаболизам омогућује да организам користи енергију и материју за све своје потребе: хомеостазу, раст, развиће, размножава
ње, кретање, дисање, излучивање, терморегулацију.
трофи.
Мали број аутотрофних организама, а то су неке бактерије, јесу хемоаутотрофи. Ови организми могу да живе
као
(ектопаразити) или унутар тела (ендопаразити)
Храну усвајају на веома различите начине, апсорпцијом површином тела, или преко различитих, специјализованих структура.
тима (Plasmodium, узрочник маларије), гљивама (медњача), биљкама (име
ATPa.
Дисање представља процесе катаболизма органских једињења током којих се ослобођена хемијска
синтезу ATPa. Енергију, у виду ATPа, организам користи у процесима анаболизма за биосинтезу
је процес који повезује путеве катаболизма и анаболизма (амфиболизам).
Скоро сви организми користе органска једињења
Само неке бактерије (хемоаутотрофи)
H2S, NH3), чијом
Гликолиза
Процес

Заокружи слово испред тачне тврдње.
У процесу аеробног дисања: а) није потребан кисеоник, б) ослобађа се енергија, в) појачани су анаболички процеси.
г) Све претходно наведене тврдње су тачне. Наведите разлике између катаболичких
а) фотохетеротрофи
б) хемохетеротрофи
в) аутотрофи
г) сапрофити
•
•
•
старе и умиру. Ћелије које
дају црвена крвна зрнца у крви сисара налазе се само у сржи дугих ко
стију. Те ћелије се непрекидно деле, замењујући црвена крвна зрнца,
Сви вишећелијски организми поседују способност регенерације

раст и развиће биљака.
способност да: 1) осете промене у спољашњој средини и 2) активно реагују на њих. Промене на које организми реагују јесу надражаји или стимулуси. Ти надражаји могу бити механички, хемијски, топлотни или светлосни. Да би открили надражаје, организми су развили механизме за пријем информација из спољашње средине. Надражаји могу да се приме површином тела (нпр. једноћелијски организми) и чулним органима, као
што су очи, уши, нос (нпр. код неких животиња), пупољци, изданци, ли
стови (код биљака). Као и код хомеостазе, регулација и повезаност реакција







•
•
•
(C),
(O),
(H),
(N), фосфор (P), сумпор (S)... Микроелементи се налазе у веома малим количинама (у траговима), и то су, на пример, гвожђе (Fe), бакар (Cu), цинк (Zn)... Значај неког хемијског елемента, међутим, не зависи од количине у којој се налази у организму.
КАТЈОНИ
Натријум (Na+)
Ванћелијски
Калијум (K+) Унутарћелијски
Ванћелијски
Калцијум (Ca2+)
Магнезијум (Mg2+)

Вода је извор живота. Живот је настао у
лијардaма година. Први организми
сније, стицањем разних адаптација, долази
ну, међутим, живот не може опстати
где воде нема. Увек је
потребна макар и минимална количина воде. Све фазе развића водених
организама одвијају се у води. Копнени организми у некој фази развића
зависе од воде. За полно размножавање маховина и папрати неопходна је вода. Семена голосеменица и скривеносеменица не могу
фотосинтезе
једињења, која су храна (тј. извор енергије) за сва жива бића. Такође се ослобађа кисеоник, који користе сви




a) pH = 3, б) pH = 7, в) pH = 9, г) pH = 11.

водоничних веза. То омогућава да вода будe изузета
топлотни изолатор
Због великог топлотног капацитета, воде океана, мора
adhaesia – приањање, лепљење)




































































се капиларна
вода, која се под утицајем капиларних сила пре
мешта, крећући се у свим правцима, из слоје
ва веће влажности у слојеве мање влажности.
Та вода је доступна биљкама, могу да је усвајају
и транспортују проводним системом све до листова. Капиларне силе омогућавају да се вода пење, насупрот гравитацији,
до великих висина (највише дрво на свету, секвоја – генерал Шерман, високо је

























O + O2O3
дуги ланци, негранати и гранати, као и прстенови. Дуги биомолекули
лекули. Макромолекули могу учествовати у
(нпр. протеини и липиди), преносу информација (нуклеинске киселине), катализи реакција (протеини), и извор су енергије (полисахариди, липиди). Атоми угљеника
и односи се на његов тродимензионални (3D) облик. Функција биомоле
кула у живим системима одређена је
конфигурацијом. На пример, активност ензима зависи

Одредите да ли је тврдња тачна (Т) или није тачна (Н).
а) Биомолекули су хемијска једињења угљеника
Еукариотска
в) Сви организми, осим бактерија, воде порекло
Допуните опште шеме фотосинтезе код биљака (a) и зелених бактерија (б).
а) 6CO2 + + 6O2
б) nCO2 + + nH2O +
Одредите који анјони или катјони:
а) граде ДНК, РНК и ATP,
б) улазе у састав желудачног сока,
в) учествују у осморегулацији,
г) учествују у контракцији мишића,
д) граде кости
Уписивањем
нијих ка сложенијим.
процеса,
Ћелије
Ћелије
Ниво глукозе опада. бр.
Панкреас бр.
Повећано лучење инсулина. бр.
Повећано лучење глукагона. бр.
Попуните табелу уписивањем знака




Кључне речи
• биомолекули
• мономери
• полимери
• биохемија
• угљени хидрати
• моносахариди
• пентозе
• хексозе
• дисахариди
• олигосахариди
• полисахариди
• хомополисахариди
• хетерополисахариди
броју угљеникових
улазе у њихов састав, можемо их поделити на: триозе, тетрозе, пентозе, хексозе и хептозе. У биохемијским
процесима најзначајнији моносахариди су пентозe и хексозе. Они се у ор-
ганизму налазе у цикличном облику.
Пентозе су моносахариди који садрже
пет атома угљеника. Најзначајније пентозе
у живом свету су рибоза и дезоксирибоза.
Њих нема у слободном облику, већ улазе у састав других органских једињења. Ри-
боза улази у састав РНК (рибонуклеинске
киселине) и ATP-а. Дезоксирибоза улази у
састав ДНК (дезоксирибонуклеинске киселине).
Хексозе садрже шест атома угљеника.
Глукоза, галактоза и фруктоза имају исти хемијски састав (исту молекулску формулу: C6H12O6), али различиту тродимензионалну структуру, због чега се разликују по својим особинама.

Слика 3.1. – Структурна формула рибозе
са. Налази се у плодовима
многих биљака, а највише
је има у шећерној трсци и
шећерној репи, па је због
тога добила име тршчани
или репин шећер. Лактоза – млечни шећер − налази се само у млеку сисара.
Лактоза се састоји од мо-
лекула галактозе и молекула глукозе. Малтоза је дисахарид који настаје разградњом скроба. Састоји се од два молекула
глукозе.
Олигосахариди

по начину повезивања моносахарида, по
дужини и разгранатости ланца. Полисахариди састављени само од једне врсте моносахарида називају се хомополисахариди. Најраспрострањенији међу њима су скроб, гликоген, целулоза и хитин, у чији састав улазе само молекули глукозе. Хетерополисахариди су састављени



полисахарид састављен од молекула глукозе, сличан целулози. Од целулозе се разликује
по томе што је једна хидроксилна група замењена амино-групом, што му
даје додатну чврстину.
Агар је полисахарид изграђен од великог броја мо-
лекула галатозе. Налази се
у ћелијском зиду неких црвених алги. Користи се као
додатак хранљивим подлогама на којима се узгајају бактеријске културе. Такође има примену у прехрамбеној индустрији, медицини и козметици.

Заокружите
Амилоза
а) галактозе,
б) гликогена,
в) целулозе,
г) скроба.
Заокружите слово испред тачне тврдње.
У састав нуклеинских киселина улазе:
а) сахароза и фруктоза,
б) рибоза и галактоза, в) дезоксирибоза и рибоза, г) фруктоза и дезоксирибоза.
Заокружите слово Т ако је тврдња тачна,
у макромолекуле. Липиди у организму имају различите улоге. Триглицериди су извор енергије и резерва енергије у оранизму. Фосфолипиди, холестерол и воскови имају градивну улогу. Стероиди су регулаторни липиди и улазе у састав неких хормона.
Триглицериди
Триглицериди (масти






нервног влакна и утиче на
његову проводљивост. Холестерол
служи као полазни молекул за синтезу стероидних хормона. Хормони имају улогу у регулацији процеса који се одвијају у организму.
Стероидни хормони код кичмењака, на пример, јесу полни хормони − прогестерон и тестостерон, као и хормони надбубрежне жлезде –
кортикостероиди.
Воскови

Заокружите слово испред тачне тврдње.
Градивну
а) холестерол, б) хитин, в) гликоген, г) фосфолипид.
Заокружите слово
Када
је користи из:
а) глукозе,
б) триглицерида,
в) фосфолипида,
г) гликогена.
Заокружите
материје. Т Н
б) Код фосфолипида се за молекул масне
киселине,
1.
2.
3.
менти који улазе у састав амино-киселина су C, H, O, N и S. У природи постоји више од петсто амино-киселина, али у састав живих бића улази само
њих двадесет. Оне се могу комбиновати на различите начине и дати велики број протеина. Бактерије, на пример, имају око 5.000, а човек око 20.000 различитих протеина. Биљке и многи микроорганизми могу да синтетишу свих двадесет амино-киселина. Животиње и човек не могу да синтетишу све амино-киселине, већ их морају унети храном у организам.
Све амино-киселине садрже амино-групу (NH2) и карбоксилну групу (COOH). Бочна функционална група амино-киселине
терцијарна структура зависи од примарне грађе, односно од распореда R-остатака у поли-
пептидном ланцу. Терцијарна структура је финални облик протеина и он тек тада, у том
своју функцију.
Кватернарна структура протеина
ни од више субјединица. Свака субјединица има своју терцијарну структуру, може се састојати од једног полипептидног
лошки
ларни протеини.
Облици протеина
Облик протеина може бити фибриларан
влакнастог об-
лика. Због своје специфичне грађе нај-
имају структурну улогу.
фибриларни протеин је колаген Он је изграђен од три полипептидна ланца у облику α-завојнице, између којих се образују водоничне везе. Сваки полипептид се увија спирално око друга два, у виду ужета. Зато је колаген веома

Хемоглобин
Класификација протеина Протеини се могу класификовати на више начина:
улози коју обављају у организму. Према саставу протеине делимо на просте и сложене. Прости протеини су изграђени искључиво од амино-киселина. Сложени протеини поред протеинског дела садрже и непротеинску компоненту. Име су добили по природи непротеинске компоненте, па могу бити: гликопротеини, липопротеини, фосфопротеини, нуклеопротеини, хромопротеини. Према облику

Фибриларни протеини су колаген, кератин и миозин. Глобуларни облик имају ензими, албумини, глобулини, актин, хистони.
Према биолошкој улози коју обављају
организму, протеини могу бити: ензими, структурни, резервни, транспортни,
бени, регулаторни.

Заокружите слово испред тачне тврдње.
Амино-киселина може имати:
а) две амино-групе,
б) карбоксилну групу и амино-групу,
в) амино-групу и пептидну групу, г) амино, карбоксилну и пептидну групу.
Заокружите слово испред тачног одговора.
Који од наведених протеина је глобуларни
протеин?
а) актин
б) миозин
в) фиброин
г) колаген Заокружите слово
јесу слабе нековалентне везе. Оне се на неким местима раскидају, поново формирају или преуређују, па протеин мења своју просторну структуру и, самим тим, биолошку активност. Протеин се може мењати кроз неколико сличних структура − конформација у обављању својих биолошких функција. Те промене се називају конформационе промене.
Ензими су протеини који конформационим променама регулишу своју активност. Сви биохемијски процеси у ћелији одигравају се у присуству ензима. Ензими су биолошки катализатори. Они убрзавају ток хемијске реакције која би
који омогућавају унутарћелијска
и ћелијска кретања. Тубулин учествује у изградњи микротубула, које
омогућавају кретање хромозома у току ћелијске деобе. Ванћелијски
структурни протеини су колаген, кератин и еластин. Они







1
2
3 – фибриноген
4
•
•
•
• антипаралелни



Нуклеотид се образује тако што се за први угљени-
фосфатна група. Азотне
које улазе у састав рибонуклеотида су А, G, C и U, док у састав дезоксирибонуклеотида улазе А, G, C и Т. Нукле-
који улазе у састав ДНК
и РНК разликују се по шећеру
и пиримидинској бази (урацил улази у састав РНК, a ти-
мин у састав ДНК).
АТР – аденозин-трифосфат је молекул сличне грађе
као нуклеотид. У састав АТР-а
улазе шећер − рибоза, азотна
база – аденин и три фосфат-
не групе.
Примарна


Број и редослед нуклеотида у молеку-
примарну



пиримидинском базом омогућено је да се ланци налазе на истом растојању целом дужином молекула ДНК, који има изглед мердевина. Окосницу дволанчаног молекула



CGTGGTAAA
је: а) тимин, б) цитозин, в) урацил, г) гуанин. Заокружите
CGUCCUAAA
CGTGGTUUU
полинуклеотидног ланца), па је број различитих молекула ДНК који може да се образује веома велики. Зато је молекул ДНК специфичан за сваку врсту. Генетичка информација се може наследити, то јест, пренети кроз генерације ћелија




у гену се по принципу комплементарности синтетише РНК. Тај процес се назива преписивање (транскрипција). Ако је, на пример, редослед нуклеотида у једном гену (молекулу ДНК) АТCGCGАC..., редослед нуклеотида у иРНК биће UАG-CGCUG...
синтезу једног полипептидног ланца. Мутација која се десила у молекулу ДНК одразиће се на редослед амино-киселина у полипептидном ланцу. Због промене редоследа нуклеотида у молекулу ДНК може доћи до промене амино-киселине у полипептиду. На пример: ако кодон CUА у иРНК одређује амино-киселину леуцин, кодон GCG аланин, а кодон GUА валин, заменом само једног нуклеотида у ДНК (уместо гуанина се налази цитозин) мења се редослед нуклеотида у иРНК, што доводи до замене амино-киселине у полипептидном ланцу. На месту леуцина
Пре мутације Редослед нуклеотида у ДНК GАТ CGC
CАТ CGC Редослед нуклеотида у иРНК GUА GCG Редослед амино-киселина
Примена биолошких макромолекула у биотехнологији
Иста основа биохемијских процеса омогућава

Заокружите слово Т ако је тврдња тачна, а слово Н уколико тврдња није тачна. а) Репликација се одвија
на потомство?
а) амино-група;
б) карбоксилна група;
в) бочна група;
г) хидроксилна група;
д) ниједна од наведених.
Заокружите слово испред тачне тврдње.
На молекулу фосфолипида разликују се два краја:
а) хидрофилна фосфатна група и хидрофобне масне киселине;
б) хидрофобна фосфатна група и хидрофилне масне киселине;
в) хидрофилна глава и хидрофилни реп;
г) хидрофобна глава и хидрофобни реп.
Заокружите слово испред тачне тврдње.
Стероиди су сврстани у групу липида зато што:
а) имају сличну грађу као липиди;
б) јесу нерастворљиви у води;
в) имају улогу у регулацији
Обележите
а-завојница бр.
ß-плоча бр.
примарна структура

1
2
3 – аденин
4 – тимин
5
6
7
8
9 – транскрипција
10 – транслација
11 – полимер
12 – водонична




•
•
•

Липиди
због чега је мембрана еластична и савитљива. Услед тога она се понаша више као течност, као гел, него као чврста материја.
Специфичан распоред протеина, липида и олигосахарида мембрану чини асиметричном (неравномерном). Неки протеини су потпуно уро-
њени у двослој липида, пролазе кроз мембрану, па се зато налазе и на спољашњој и на унутрашњој страни мембране. Такви протеини, називају се трансмембрански. Садрже канале кроз које материје с малим молеку-
У сас таву мембране прокариота и
биљака не налази се холестерол. Нај-
више заступљени липиди мембра-
не су фосфолипиди, који су полар-
ни (разликују се два њихова краја –пола).
Захваљујући томе они формирају два слоја у мембрани, тако
што се репови групишу у средини, а главе се окрећу према споља.
Тако образовани двослој фосфолипида чини основу ћелијске мембране. Фосфолипиди
































































2. размена материја с околином, 3. примање надражаја из средине у којој се ћелија налази,
4. заштита ћелије од губитка воде и јона, одржавање хомеостазе,
5. ендоцитоза и егзоцитоза
пермеабилна
што ћелији омогућава да контролише размену материја, чиме штити сталност састава унутрашње средине (хомеостаза). Практично је непро-
пустљива за крупне молекуле (макромолекуле), релативно је непропустљива за наелектрисане јоне, а пропушта мале молекуле растворљиве у
липидима и гасове. Постоје два основна начина на које ћелија обавља размену материја с
околном средином:
1. транспорт малих молекула кроз
микроскопом
2. уношење

Наведите
Дефинишите



































Осмоза је дифузија воде кроз мембрану низ градијент водног потенцијала. Јавља се спонтано (без трошења
концентрацији у ћелији (имају исти осмотски притисак). У крви човека
се
зе у изотоничним условима. Када се еритроцити ставе у епрувету с раствором који није изотоничан, вода ће тежити да прође кроз ћелијску мембрану еритроцита да би се изједначиле количине воде с обе стране мембране. У хипертоничном раствору (концентрованији од раствора у самим еритроцитима) вода излази из еритроцита (губе воду) и запремина им се смањује. Мембрана еритроцита постаје наборана и смежурана. У хипотоничном раствору


АТP-азне пумпе. Најбоље проучена је натријум-калијум
из ћелије, а упумпава јоне калијума у ћелију. Натријума има


од наведених типова транспорта. Ћелија користи посебне методе за уношење и избацивање таквих молекула, тако

Повежите
1
2
3
4










1.
2.

(амино-киселине,
(протеини,









нови молекули с корисним информацијама могли су се наследити и даље развијати, мењати. У такве ћелије су кроз мембрану

су живеле слободно у природи, као преци митохондрија ушле су у неку крупну прокариотску ћелију (домаћин). Та ћелија је претрпела одређене еволуционе промене и тиме постала предак савремене еукариотске ћелије. Данас се зна да је ћелија домаћин била нека археа, док је ћелија која је у њу ушла била нека тадашња бактерија. Бактерија (симбионт) и њен домаћин археа заједно су еволуирале, уз обострану корист (симбиоза).
Највероватнији разлог за појаву ендосимбиозе било је нагло повећање количине слободног кисеоника у атмосфери. Појавиле су се аеробне бактерије, које су оствариле ендосимбиозу с неком археом и постале њене митохондрије. Митохондрије су промениле метаболизам ћелије домаћина, чиме су омогућиле еволуцију осталих




Кључне речи
• прокариоти
• еукариоти
• нуклеоид
• мезозоми
• ћелијски зид
• конјугација
• трансформација
• трансдукција

везани за ћелијску мембрану. За мембрану је најмање на једном месту везана ДНК, прокариотски хромозом. Такође, за мембрану се везују и протеини који учествују у репликацији бактеријског хромо-
зома и у деоби. Важно је напоменути да неке врсте бактерија поседују унутарћелијске мембране. Познати су мезозоми – уврати ћелијске мембране који повећавају укупну површину мембране и везују бактеријски хромозом. Цијанобактерије поседују уврате мембране (тилакоиде) за које су везани пигменти и ензими који учествују у фотосинтези. Ћелијски зид прокариота је јединствен по саставу и никада не садржи целулозу. Његово
Прокариоти

4.20. – Деоба бактерије

вакцинацијом, исправном хигијеном, пастеризацијом (загревањем до 60°С) и стерилизацијом (загревањем испод тачке кључања), а лече се антибиотицима.
Еукариотска ћелија
Еукариотске ћелије (грч. eu – прави, истинит, karyon – једро; „право једро”) имају потпуно оформљено једро (нуклеус), одвојено нуклеусним овојем (изграђеним од две мембране) од остатка ћелије. Ћелијска мембрана даје облик ћелији



Кључне речи
• нуклеус
• хроматин
• хетерохроматин
• еухроматин
• хистони
• нуклеозом
• нехистонски протеини
• хромозоми
• кариотип
• диплоидан број (2n)
• хаплоидан број (n)
• сестринске
хроматиде
• центромера
• кинетохор
• нуклеолус

једра излазе у цитоплазму тРНК, иРНК, као и субјединице рибозома. Број
Пре почетка деобе ћелије кондензују се хроматинска влакна, тако да
она постају уочљива – хромозоми.
Врсте хроматина
Према јачини бојења, разликују се две
врсте хроматина: хетерохроматин и
еухроматин. Хетерохроматин је кондензован, па је због тога тамније обо-
јен и лако се уочава у једру. Еухро-
матин је дифузан (расплетен), па је услед тога светлије обојен. Ћелије које
интензивно синтетишу неки протеин имају мало хетерохроматина, а доста еухроматина – њихова једра су светлија. Еухроматин је активан у транскрипцији. У хетерохроматину



чове-
ка има 46 хромозома или две
гарнитуре по 23 хромозома, при чему једна гарнитура потиче од мајке, а друга од оца.

Полне ћелије или гамети (код човека су то сперматозоиди и јајне ћелије) садрже упола мањи број хромозома у односу на телесне ћелије. Број хромозома у полним ћелијама назива се хаплоидан и обележава се са n (грч. haploos – једнострук). Ако телесна ћелија има две гарнитуре хромозома, полна ћелија имаће једну гарнитуру хромозома. Број хромозома у полним ћелијама човека је 23. Колико копија сваког
сестринске хроматиде и центромере. Те делове садрже сви хромозоми, док се само код неких јавља и секундарно сужење.

Сестринске хромати-
де образују се дупликацијом ДНК, па су потпуно једнаке, садрже исте гене (отуда назив сестринске).
Свака хроматида је уздужна
половина хромозома и има један молекул ДНК, а цео хромозом има два једнака



Заокружите слово
в) изграђени од хетерохроматина.
д) Тачне су тврдње под а) и б).
Заокружите слово испред тачне тврдње.
У ћелији се за време деобе може уочити:
а) нуклеус,
б) нуклеолус,
в) хроматин, г) хромозом.
Заокружите слово испред тачне тврдње.
Метафазни митотски хромозом се састоји од:
а) две сестринске хроматиде,
б) две центромере,
в) два кинетохора,
г) свега претходно наведеног.
д) Тачне су тврдње под а) и в).
Заокружите слово испред тачне тврдње. Ми-
шићна ћелија човека садржи: а) 44 хромозома, б) 23 пара хромозома,
в) две гарнитуре са по 46 хромозома, г) хаплоидан број хромозома.
Са чиме је у вези перинуклеусни простор?
Коју улогу имају хистонски протеини у хроматину?
У којим процесима












нуклеолус, бр. спољашња мембрана


хроматин, бр.
садрже исте гене.
Да ли је тачно рећи да је нуклеолус
































Цитосол и цитоплазма
Цитоплазма
од осталих рибозома у ћелији (ситнији су, слични прокариотским рибозомима).


Ендоплазмин ретикулум (ендоплазмина мрежа)
Ендоплазмин ретикулум (скраћено ЕР) састоји се од мембрана које ограничавају унутрашње просторе (цистерне) и пружају се
reticulum
ретикулума:
гранулисани (гЕР) и
− агранулисани (аЕР).
Гранулисани ендоплазмин ретикулум

полирибозома на површини мембране која је окренута ка цитоплазми (отуда назив гранулисан, лат. granum – зрно). Његове мембране образују цистерне, које су најчешће постављене паралелно. Мембране и цистерне гЕР-а настављају се на спољашњу мембрану нуклеусног







Органеле за разградњу
Лизозоми
Лизозоми (lysis – разлагање; soma – тело) јесу мембранске органеле у
за унутарћелијску разгра-

Вакуоле
Вакуоле су мембранске органеле биљне ћелије које
имају функцију ендозома и лизозома ћелија животиња. Мембрана вакуоле се назива тонопласт.
Ћелија може да има различит број вакуoла, и то различитих величина, што највише зависи од њене старости. Младе ћелије садрже више ситних вакуола. Зреле ћелије имају једну крупну, централно постављену вакуолу. Она потискује цитоплазму с ћелијским органелама уз ћелијски зид. Вакуоле садрже хидролитичке ензиме, који могу да разлажу различите материје. Осим тога, имају улогу у складиштењу хранљивих материја и одржавању чврстине ћелије (сок у вакуоли одржава ћелијски тургор). Сок у вакуоли може


АТР се, осим у митохондријама и хлоропластима, продукује и у цитоплазми, али је тај принос сиромашан. Разградња глукозе почиње у цитоплазми, а завршава се у митохондријама.
Митохондрије
Митохондрије су довољно велике да се могу
светлосним микроскопом, због
19. веку (1857. године).
Митохондрије су изграђене

се
респираторног транспортног ланца, који омогућују
се митохондрије популарно називају „електране”.
лазе рибозоми, митохондријска ДНК и ензими који учествују у метаболичким процесима оксидације масних киселина и лимунске киселине (Кребсов циклус).
Рибозоми (називају
1. хлоропласти (грч. chloros – зелен),
2. хромопласти (грч. chromа – боја),
плодовима и цветовима, па је једна од њихових улога еколошка (привлачење инсеката, разношење плодова),
3. леукопласти (грч. leucos – бео), који немају пигменте; њихова улога је складиштење хранљивих материја (скроба, уља, протеина). Сва три типа пластида

строме повезују тилакоиде грана
образујући тако један систем у виду мреже.
У мембранама тилакоида налазе се пигменти
и ензими који учествују у светлој фази фото-
синтезе.
У строми хлоропласта налазе се:

1. рибозоми, ситнији од оних у цитоплазми, слични прокариотским рибозомима;
2. хлоропластна ДНК (хДНК), прстенастог облика (слична прокариотској ДНК); има способност удвајања, па и хлоропласти могу да се деле независно од деобе једра:
3. грануле скроба, у којима се складишти глукоза створена у фотосинтези:
4. многобројни ензими, који учествују у тамној фази фотосинтезе.
Слично митохондријама, и хлоропласти могу
се дуплирају независно од деобе једра. При полном размножавању

контрактилно













центриола.


Заокружите слово испред тачне тврдње.
Структуре које биљна ћелија НЕ садржи су:
а) рибозоми, б) центриоле, в) митохондрије, г) вакуоле.
Заокружите слово испред тачне тврдње. По-
кретање органела унутар ћелије омогућава: а) цитоскелет, б) цилија (трепља), в) Голџијев апарат, г) центриола.
Шта митохондријама омогућава
синтезу сопствених протеина? Наведите

Кључне речи
• ензими
• активни центар
• метаболичка мрежа
• анаболизам
• катаболизам
• фосфорилација
• аденозин-трифосфат (ATP)
• аденозин-дифосфат (АDP)
• аденозин-монофосфат (АМP)
• енергетска хомеостаза

активност ензима је највећа. Метаболизам
организма, размножавање,
друго, док се хемијска енергија употребљава у анаболизму,















Две крајње фосфатне
групе везане су ковалентним везама које су богате
енергијом. Када се те везе разграде, ослобађа се одређена количина енергије. Када се из АТР-а ослободи је-
дна крајња фосфатна група, настаје аденозин-дифосфат (АDP), а издвајањем још једне крајње фосфатне
групе из АDP-a настаје аденозин-монофосфат (АМP).
Фосфатна група, која се
ослободила из АТP-а или АDP-а, богата је енергијом и

везујући се за неко једињење она и њега обогаћује енергијом
начин се енергија
процесима: гликолизи, фотосинтези и ћелијском дисању. Почетна






























Кључне
• азотофиксатори
• нитрификација
•
•
•
•
функционисање ензима који је одговоран за
фиксацију азота. Aко анализирамо азотофиксаторске фо-
тосинтетичке цијанобактерије, могли бисмо рећи да су то организми који су сами себи
довољни. Њима су потребни само угљен-диоксид и неке неорганске супстанце за мета-
болизам, а све остало су у стању да саме обе-
збеде. Због тога ови облици јесу





је променило то мишљење. Тај
дубини 800–4.000 m у областима с великом вулканском активношћу.

Укратко

Фотосинтеза је основни процес у
зато што обезбеђује органске материје за све живе организме. Она представља
Фотосинтетички пигменти Фотосинтетички пигменти, који
се ослобађа у атмосферу, што је још један допринос фотосинтезе. Живот на нашој планети заснива се на претварању Сунчеве енергије у хемијску и на коришћењу атмосферског кисеоника за дисање. У тамној фази фотосинтезе користе се АТP и NADPH створени у светлој фази. ATP служи као извор енергије, а NADPH даје електроне за редукцију угљеника из угљен-диоксида до шећера. Угљен-диоксид (биљка га усваја из атмосфере) јесте извор неорганског угљеника који се уграђује у органска једињења. Претварање неорганског угљеника у органски угљеник (шећер) нази-
ва се фиксација угље-
ника и врши се у
Калвиновом циклусу. Сваким циклусом у њега улази један мо-
лекул угљен-диоксида
и везује се за почетно једињење (шећер са
пет угљеникових атома). У даљем току циклуса помоћу ATP и
NADPH настају различити шећери и регенерише се почетно једињење.
садрже велику количину хлоропласта, па се у том ткиву фотосинтеза одвија најинтен-
зивније. Ћелије сунђерастог ткива су ра-
здвојене крупним интерцелуларима и зато је ово ткиво растресито, шупљикаво као сунђер. Кроз интерцелуларе се врши размена гасова у ткивима листа. Проводни снопићи се састоје од ксилема (окренут ка
лицу листа, проводи воду и неорганске материје) и флоема (окренут ка наличју листа). Осим проводних снопића, заступљена су механичка ткива (ликина влакна, коленхим). Проводни систем листа повезан је с
проводним системом стабла.
Спољашњи фактори који утичу на фотосинтезу Утицај на фотосинтезу имају унутрашњи фактори (генотип, количина хлорофила, старост листова, положај листова) и спољашњи фактори Спољашњи фактори су водени режим и минералне соли, температура, концентрација угљен-диоксида, концентрација кисеоника и светлост. Сваки од ових фактора може да буде ограничавајући












C6H12O6 + 6O2 6CO2 + 6H2O + ATP. У ћелијама хетеротрофних организама
извор енергије је глукоза, чијим се разлагањем (оксидацијом) ослобађа енергија. Ту енергију
ћелија чува у облику молекула АТР-а. Митохондрије су главна места
дукције ATP-а.
Ћелијско дисање одвија се
1. гликолиза,
2. оксидација пирувата,
3. Кребсов циклус и
4. оксидативна фосфорилација.
Гликолизом се један молекул глукозе разложи на два молекула пирувата (пирогрожђане киселине).
употребљава за стварање два молекула ATP-a и два молекула редукованог
(анаеробно). Пируват још увек садр-
жи велику количину потенцијалне енргије коју је глукоза садржала. Када у ћелијама човека недостаје кисеоник (анаеробно дисање), у условима његове повећане по-
трошње, пируват се претвара у млечну киселину (лактат), чиме се регенерише NAD (његов недостатак би довео до смрти ћелије). Во-


павање” протона из матрикса у простор између спољашње и унутрашње мембране митохондрије. Тиме настаје рaзличита концентрација протона с две стране унутрашње мембране, чиме се ствара потенцијална енергија. Када се протони врате у матрикс, та енергија се ослобађа и употреби за синтезу АТP-a из ADP-a. Такво стварање ATP-а је оксидативна фосфорилација.

Анаеробни метаболизам У анаеробним условима
Lactobacillus
(добијање јогурта, сирева и др.). Алкохолним врењем,
врше неки квасци (нпр. из рода Saccharomyces, коме припадају пекарски, пивски, вински квасац и др.), из пирувата се добија






Заокружите слово испред тачне тврдње.
Ћелијска мембрана изграђена је од:
а) липида, протеина и олигосахарида;
б) липида, воде и угљених хидрата;
в) протеина, воде и олигосахарида;
г) воде, протеина и липида.
Допуните реченицу тако што ћете
У активном транспорту
и троши се .
а) протеини
б) енергија
в) вода г) липиди
д)
3
4
5
6









































































































































Кључне речи
• интерфаза
• пресинтетичка фаза (Г1)
• синтетичка (С) фаза
• постсинтетичка (Г2) фаза
• бинарна деоба

зато што се током те фазе обављају обимне припреме за деобу. Под микроскопом се у интерфази, осим увећања
дељења, као што су нервне ћелије, мишићне ћелије срца или, на пример, еритроцити, уласком у Г1 фазу у њој
трајно остају. Пошто Г1 фаза истовремено представља читав ћелијски ци-
клус ових ћелија, она се у том случају означава као Г0 фаза. Ћелије које се током целог свог живота налазе у Г0 фази називају се нецикличне ћелије. Оне свој животни век окончавају ћелијским умирањем, а ћелије које имају способност деобе завршавају свој живот деобом на нове ћелије.
Током С-фазе у једру се врши репликација ДНК (самодупликација ДНК). Сваки хромозом, који је у
за деобно вретено) и органеле које
ће се расподелити „кћеркама” ћелијама у деоби. Пошто се одвија после репликације, у




•
•
ћелије за
обављање одређене функције.
Диференцијација је процес током развића којим се ћелије или групе ћелија
мењају морфолошки и физиолошки, чиме се специјализују
одређене функције. Дешава се искључиво у живим системима и њиме се
постиже разноврсност облика, структуре и функције. Почетне ћелије су
ембрионске ћелије, а ћелије које настају
Додатни текст
На самом почетку ембрионалног развића, а као резултат узастопних митоза, формира се прво морула (облика дудиње), а затим лоптаста бластула. Морула и бластула су једнаке величине
као оплођена јајна ћелија.



фаза, метафаза, анафаза
телофаза (поређане су по редоследу дешавања). Сваку фазу карактерише одређен положај хромозома унутар ћелије. На самом почетку митозе хромозоми се уочавају као дугачки конци, по чему је и

тида.
микротубула деобног вретена за кинетохоре назива се као „нађи и ухвати”. Микротубуле се
много пута пружају ка хромозому, додирују га тражећи кинетохор све док га не нађу, а затим се за њега закаче. Хромозоми су све кондезованији и све више се померају ка екватору ћелије. Деобно вретено (митотско вретено) јесте структура која се у ћелији образује од микротубула за време деобе и одговорна је за кретање хромозома. Образовање деобног вретена почиње у профази, а завршава се у метафази митозе и мејозе. Нити деобног вретена изграђене су од огромног броја микротубула (5.000–10.000) и различитих протеина (један од основних је тубулин). Пружају се од полова ћелије, на којима се налазе парови центриола (центрозоми), ка екватору, на ком се налазе хромозоми. Поред нити које се везују за хромозоме, постоје
















Кључне
• мејоза
•
•
•
•
•
•
•
•
се
хромозома у „кћеркама” ћелијама у односу на „мајку” ћелију смањује напола, та деоба

материјала између хомологих хромозома назива се кросинг-овер (енгл. crossing-over – „прелазак преко”).
синг-овера хромозом


пропадају.
Животни циклус еукариота – смена хаплоидне и
диплоидне фазе
који су скоро читавог живота хаплоидни (нпр. већина гљива). Сматра се
да су диплоидне ћелије настале рано у
Животни циклуси скоро свих данашњих еукариота имају смену диплоидне и хаплоидне фазе:
1. код биљака и многих алги смењују се две вишећелијске фазе (називају се генерацијама): спорофит (диплоидна генерација) и гаметофит (хаплоидна генерација);
2. код животиња је доминантна диплоидна фаза (вишећелијски организам који расте и развија се митозама једне ћелије, зигота), док су полне ћелије једине хаплоидне ћелије (формирају се
3. код































Упоредите анафазу митозе с анафазом мејозе I.
Колико ланаца ДНК
д) ћелије са 46 молекула ДНК код човека.
Заокружите слово испред тачне тврдње.
Један целовит ћелијски циклус обухвата:
а) митозу и мејозу;
б) митозу, Г1, С и Г2 фазу;
в) Г1, С и Г2 фазу; г) Г2 фазу и мејозу.
Заокружите слово испред тачне тврдње.
Обнављање дотрајалих ћелија
а) митотичким деобама;
б) мејозом I;
в) мејозом II;
г) бинарном деобом; д) ниједном од наведених
2















2




Кључне речи
• савремена
теорија
•
•
– настанак молекула који носе информацију
настанак првих ћелија; – појава фотосинтезе;
настанак еукариотске ћелије; – настанак вишећелијских организама;
– појава полног размножавања.
Пребиотичка

мешавине
гасова и изворе енергије, мењајући услове у складу с
новим научним сазнањима. На тај начин добили

















Кључне
• „пребиотичка супа”
• хидротермални
•
• прагени
• протоћелија
• појава
фотосинтезе
• хемијски фосили
• строматолити
Подсетите се

РНК.
Генетичка информација се затим ,,преселила” у ДНК. У сложеним
хемијским реакцијама РНК света најпре су се појавиле основне градивне компоненте ДНК. Појава посебног





Кључне речи
• дрво живота
• LUCA
• ендосимбиотска теорија
• постанак једра
• организација хромозома
еукариота
• настанак вишећелијске организације
• појава полне репродукције
Додатни текст
Генетички код (шифра) је скуп правила
повећавала. Докази да митохондрије и хлоропласти потичу од прокариотских
предака су многобројни. Ове органеле, на пример, имају сопствену ДНК, која је организована као бактеријски хромозом, и деле се независно од деобе саме ћелије, а имају и сопствене рибозоме, који су слични рибозомима прокариота. Поред тога, спољашња и унутрашња мембрана органеле се разликују.
Анализе предачко-потомачких односа (филогенетске анализе, о којима ће бити речи касније) показују да су митохондрије настале од пурпурних несумпорних бактерија, а хлоропласти од цијанобактерија. О постанку једра, кључне одлике еукариотске ћелије, још увек не постоји сагласност – да ли је настало













Кључне речи
• заједничко
порекло
• еволуција
•
• филогенија
• филогенетско стабло
•
•
•
•
могу представити на различите начине. Битан је
гранања током времена, а не редослед којим представљамо групе организама на крајевима грана (то јест, групе савремених
исто.
обзиром на то да не можемо
директно посматрати промене живог света у прошлости, сродничке
односе савремених организама одређујемо проучавајући њихове особине. Класичан начин реконструкције филогенетских стабала засни-
различито.
сврставањем у групе (класификацијом). Она обухвата филогенију, која се бави предачко-потомачким односима, и

сродне врсте гру-
пишу се у род, родови у породицу, породице у ред, а редови у
класу. Сродне класе чине тип или раздео, а сродни типови од-
носно раздели групишу се у царство. Највиша категорија, изнад
нивоа царства, јесте домен. Живи свет се дели, као што смо ра-
није навели, на три домена. Домен еукариота (Eukarya) обухвата четири царства, а домени археа (Archаea) и бактерија (Bacteria)
по једно царство.
ДоменEukaryaEukarya Bacteria
ЦарствоPlantaeAnimalia Eubacteria
Тип/раздеоTracheophytaChordataProteobacteria
КласаMagnoliopsidaReptiliaEpsilonproteobacteria
Ред FagalesSquamataCampylobacterales
Породица FagaceaeViperidaeHelicobacteraceae
Род QuercusVipera Helicobacter
Врста Quercus roburVipera ammodytesHelicobacter pylori







Кључеви за идентификацију (дихотоми
кључеви) представљају скуп упутстава помоћу којих можемо да идентификујемо непознате ор-
ганизме. Идентификација се одвија корак по корак, коришћењем различитих особина организама. Дихотомија се


Заокружите слово испред тачне тврдње.
Атмосфера првобитне Земље по саставу је била:
а) са мало или нимало слободног кисеоника, а богата водоником;
б) са мало или нимало слободног водоника, а богата кисеоником;
в) са мало или нимало слободног метана, а богата водоником; г) са
кисеоником.
Заокружите слово испред тачне тврдње.
Извор угљеника у „праатмосфери”
а) амонијак,
б) метан,
в) угљен-моноксид,
г) етан.
Заокружите слово испред тачне тврдње.
Прагени
а) олигорибонуклеотиди,
б) олигодезоксирибонуклеотиди,
в) олигопептиди,
г) олигосахариди.
Допуните















LUCA (акроним од „последњи универзални
заједнички предак“ на енглеском) je последњи
заједнички предак свих живих бића на Земљи.
Агар је хомополисахарид изграђен од великог
броја молекула галактозе који се налази у ће-
лијском зиду неких црвених алги.
Адаптација је процес којим организам постаје
боље прилагођен за живот у свом станишту.
Аденозинтрифосфат (скр. ATP) јесте нуклеотид који се састоји од аденина за који је везана
рибоза, а за њу у низу три фосфатне групе, од
којих су две крајње везане ковалентним везама
богатим енергијом.
Адхезија (лат. adhaesia – приањање, лепљење) јесте привлачна сила између молекула различи-
супстанци.
Аеробни организми су сви организми којима је
за дисање неопходан кисеоник.
Азотна база је део нуклеотида ДНК и РНК
(цитозин, тимин и урацил).
Аклиматизација представља постепене, повратне реакције организма на промене у спољашњој средини.
Активан транспорт кроз ћелијску мембрану обавља се тако што се материје помоћу протеина носача и уз
Биогени елементи су хемијски елементи који улазе у састав ћелија живих организама.
Биологија је наука о животу; назив ове науке је кованица настала од две грчке речи: bios, што значи живот, и logos – учење, наука.
Биомолекули су молекули који се формирају у организму и граде организам.
Биотехнологија је научна дисциплина која проучава и користи
Г
Гамети
Генске
је процес генетичких промена у популацијама кроз време, у сложеним интеракцијама са средином.
Егзоцитоза (секреција, излучивање) је
специфичних
ћелије или неких других материја у ванћелијску средину.
Ендоплазмин ретикулум је органела која се састоји
(цистерне) и пружају се готово кроз читаву ћелију попут мреже (лат. reticulum – мрежа).
Ензими су протеини који катализују све
неуређености система.
Еукариоти су организми (припадају
Капиларност
Микротубуле (микроцевчице) јесу делови цитоскелета у облику шупљег цилиндра
Микрофиламенти (лат. filamentum – конац, нит) јесу делови цитоскелета,
Митоза
Митохондрије
резултат
Неорганске
је унутрашњост једра одвојена од цитоплазме нуклеусним овојем, а у којој се налазе хромозоми – хроматин и једарце.
Нуклеотиди су основне јединице грађе нуклеинских
или селективна пропустљивост мембране је особина
трисане
Постсинтетичка фаза (Г2) јесте период интерфазе ћелијског циклуса
следи после синтетичке фазе, а пре деобе.
Прагени су први самореплицирајући олигону-
Речник
Природне
метода.
Прокариоти
Прокариотска
Протеини (proteos – најважнији, први) су полимери изграђени од мономера
Профаза је прва фаза у митози и мејози.
Пуринске базе су двопрстене азотне базе које улазе
је област биологије која проучава сродничке односе организама
Редукција
у „кћеркама” ћелијама формирају се једра.
Терцијарна структура протеина настаје повезивањем R-остатака амино-киселина.
Технологија је
о вештинама и
чија је сврха прерада природних сировина за људску употребу.
Течно-мозаички
све
функције. Ћелијске органеле су одељци у ћелији организовани ћелијском мембраном
Хаплоидан
ма угљеника.
Хемицелулоза је хетерополисахарид, полимер глукозе и других хексоза и пентоза.
Хемоаутотрофи као извор енергије у хемосинтези користе неорганске молекуле, као што су H2, H2S, NH3.
Хемотрофи су организми
већ
које је могуће тестирати, проверити, како би се утврдило да ли јесте или није тачно.
Хитин је хомополисахарид изграђен од молекула
глукозе, главна је компонента спољашњег ске-
зиду неких гљива.
Хлоропласти (грч. chloros – зелен) јесу врста пла-
стида који врше фотосинтезу.
Холестерол је врста стероида у мембранама животињских ћелија којима даје
ниским температурама. Хомеостаза (грч. homoios – сличан; stasis
оби.
Цитоплазма представља
Lewin, B.: Cells, Jones & Bartlett Publishers, 2007.
McGraw-Hill Ryerson: High School Biology 11, електронско издање
McGraw-Hill Ryerson: High School Biology 12, електронско издање
Wise, R. R., Hoober, J. K.: The Structure and Function of Plastids, Springer, 2007.
Вујаклија, М.: Лексикон страних речи и израза, Просвета, Београд, 2006.
Глишић, Р., Обрадовић, Ј.: Практикум
радном свеском, ПМФ, Крагујевац, 2011.
Глишић, Љ.: Општа цитологија, Унија биолошких научних друштава Југославије, Београд, 1980.
Гроздановић-Радовановић, Ј.: Цитологија, ЗУНС, Београд, 2000.
Давидовић, В.: Физиологија I, ЗУНС, Београд, 2003.
Цветковић, Д., Лакушић, Д., Матић, Г., Кораћ, А., Јовановић, С.: Биологија за 4. разред гимназије природно-математичког смера, ЗУНС, 2004.
Пантић, Р. В.: Биологија ћелије, Универзитет у Београду, Београд, 1997.
Трпинац, Д.: Хистологија, Кућа штампе, Београд, 2001.
Шербан, М. Н.: Покретне и непокретне ћелије – увод у хистологију, Савремена администрација, Београд, 1995.
Шербан, М, Н.: Ћелија – структуре и облици, ЗУНС, Београд, 2001.
Трифуновић, С.: Биологија за први разред медицинске школе, Завод за уџбенике, Београд, 2020.
I тема: Биологија као природна наука
Више о биологији као природној науци: https://www.britannica.com/science/biology
Више података о развоју цитологије: http://www.bionet-skola.com/w/Razvoj_i_dostignu%C4%87a_ citologije
Преглед биологије и интерактивне лекције: https://www.khanacademy.org/science/high-school-biology/ hs-biology-foundations/hs-biology-and-the-scientific-method/v/overview-of-biology
Видео-материјали: https://www.youtube.com/user/biointeractive
II тема: Особине живих бића
Питања за вежбање
https://assets.cambridge.org/97805216/80547/excerpt/9780521680547_ excerpt.pdf
Интерактивна лекција: https://www.khanacademy.org/science/in-in-class-11-biology-india/ x9d1157914247c627:the-living-world/x9d1157914247c627:introduction-to-the-living-world/a/what-is-life
Интерактивна лекција: https://openoregon.pressbooks.pub/mhccbiology101/chapter/properties-of-life/
Видео-записи, фотографије и интерактивне лекције: https://www.ck12.org/biology/Characteristics-ofLife/lesson/Characteristics-of-Life-Advanced-BIO-ADV/
III тема: Биолошки макромолекули
Видео о регенерацији: https://www.youtube.com/watch?v=byLDgtSMI0w
Анимација ДНК, транскрипцијe, транслацијe, репликацијe: http://www.johnkyrk.com/DNAanatomy. html
Текст о урацилу у ДНК: http://www.scienceinschool.org/sr/2011/issue18/uracil
Игрица о структури ДНК: https://www.nobelprize.org/educational/medicine/dna_double_helix/dnahelix. html
Анимација ДНК, РНК: http://www.stolaf.edu/people/giannini/flashanimat/molgenetics/dna-rna2.swf
Анимација транскрипције: http://www.biologieenflash.net/animation.php?ref=bio-0025-2
транслације: http://www.stolaf.edu/people/giannini/flashanimat/molgenetics/translation.swf
https://highered.mheducation.com/sites/0072943696/student_ view0/chapter3/animation__dna_replication__quiz_1_.html
https://highered.mheducation.com/sites/0072943696/student_ view0/chapter3/animation__how_translation_works.html
https://highered.mheducation.com/sites/0072943696/student_ view0/chapter3/animation__mrna_synthesis__transcription___quiz_1_.html
Унутрашњост ћелије: http://learn.genetics.utah.edu/content/cells/insideacell/ Игрица о ћелијским органелама: https://www.nobelprize.org/educational/medicine/cell/game/index.html
Биљна и животињска ћелија: https://www.youtube.com/watch?v=4PMzLCaKkCY
Ћелијске органеле и структуре: https://www.youtube.com/watch?v=KIFdOsnmOco
Центромера и кинетохор: http://www.bionet-сkola.com/w/Su%C5%BEenja_na_hromozomu
Анимација биљне и животињске ћелије: http://www.cellsalive.com/cells/cell_model.htm
Текст, слике и видео-материјали о ћелијској мембрани
https://www.britannica.com/list/fast-facts-about-the-cell-membrane
Анимација транспорта материја кроз мембрану: http://www.wiley.com/legacy/college/boyer/0470003790/ animations/membrane_transport/membrane_transport.htm
Анимације о процесима у ћелији: http://vcell.ndsu.nodak.edu/animations/ Више о ендосимбиози https://evolution.berkeley.edu/evolibrary/article/_0_0/endosymbiosis_04 Веб-пројекат Tree of life (дрво живота) са еволуционом историјом различитих врста: http://tolweb.org/ tree/
Анимација ћелијског циклуса: http://www.cellsalive.com/cell_cycle_js.htm
Анимација митозе и мејозе: https://www.cellsalive.com/mitosis_js.htm
Анимације
http://www.stolaf.edu/people/giannini/flashanimat/celldivision/crome3.swf Анимација
http://highered.mheducation.com/olcweb/cgi/pluginpop.cgi?it=swf::535::535::/sites/dl/ free/0072437316/120073/bio14.swf::Mitosis%20and%20Cytokinesis
Разлике између митозе и мејозе: http://svet-biologije.com/zanimljivosti/zanimljivosti-iz-biologije-celije/ razlike-izmedu-mitoze-i-mejoze/ Више података о мејози: http://www.bionet-skola.com/w/Mejoza
Игрица о ћелијском циклусу: https://www.nobelprize.org/educational/medicine/2001/cellcycle.html
Интерактивно дрво живота, еволуционо стабло, класификација, биодиверзитет: https://www.onezoom. org/
дрво живота: https://www.evogeneao.com/en
стабла: https://evolution.berkeley.edu/evolibrary/article/0_0_0/evotrees_intro
риба: https://evolution.berkeley.edu/evolibrary/article/ fishtree_01 Постанак
https://media.hhmi.org/biointeractive/click/deeptime/
http://exploringorigins. org/timeline.html Милеров експеримент: https://learninglink.oup.com/access/content/hillis-3e-student-resources/hillis3echapter-3-animation-5
Решење теста 1
1. б); 2. б); 3. а); 4. а2; б3; в4; г1; 5. 3, 5, 4, 2, 1, 6, 7; 6. Повећањем количине CO2 у атмосфери повећава се просечна годишња температура.
Решењe теста 2
1. а) б); 2. а) Т; б) Н; в) Н; г) Н; 3. а) 6H2O, C6H12O6, б) nH2S, (CH2O)n, 2nS 4. a) фосфати; б) хлориди; в) натријум; г) калијум и калцијум; д) калцијум;
5. 8-1-2-5-9-3-10-6-7-4;
6. А – 4; Б – 5; В – 3; Г – 1; 7. Ћелије тела разграђују глукозу – бр. 8, Ћелије јетре разграђују гликоген – бр. 9, Ниво глукозе расте – бројеви 1 и 5, Ниво глукозе опада –
бројеви 2 и 4, Панкреас
Решење теста 3 1. в); 2. а); 3. б); 4. α-завојница – бр. 2; β-плоча – бр. 3; примарна структура – бр. 1; терцијарна структура – бр. 4; 5. А – 4; Б
2;
3; В – 1; 8. AAUCGCAUCAG; 9. ДНК 2, 4, 8 1, 5 10 6 3, 9 7, 11, 12 РНК протеин
10. Синтетисаће се протеин човека. Протеин се синтетише према информацији садржаној у иРНК.
Решење теста 4
1. а; 2. а), б);
3. А − 3; Б – 3; В − 2; Г − 1; Д − 4;
4. А: 1; Б: 3, 5; В: 2, 4, 6 5.
Ферментација Аеробно дисање Оба процеса
Неопходан је
Производи се ATP. +
Неопходна је
глукоза. +
Врши се у
митохондријама. +
Глукоза се
разлаже на воду и CO2
6. 1 – угљен-диоксид; 2 – Сунчева светлост (енергија); 3 – глукоза; 4 – вода; 5 – кисеоник; 6 – ATP
7. 3, 5, 1, 2, 4
8. организам 1 – биљка; организам 2 – животиња; организам 3 – бактерија млечно-киселинског врења (или бактерије из рода Lactobacillus); организам 4 – квасци алкохолног врења (или квасци из рода Saccharomyces)
9. Треба повећати интензитет светлости и количину угљен-диоксида.
Решењe теста 5
1. б), в); 2. б); 3. а); 4. 1Б, 2Г, 3А, 4В; 5. а) 80; б) 20; 6. 1Д, 2 А, В, Г, 3Б; 7. 6, 5, 2, 4, 1, 3; 8. 2, 3; 9.
митоза 5 41 3, 8 7 2 6
мејоза I
мејоза II 10. a) 128; б) 64; в) 32.
Решење теста 6
1. д); 2. а); 3. б); 4. a); 5. б), в); 6. а) Т, б) Н, в) T; 7. 1 – заједнички предак; 2 – бактерије; 3 – архее; 4 – еукариоти; 5 – протисти; 8. А – 3, Б – 1, В –2, Г – 5; 9. 3, 1, 2, 4, 6; 10. а) А и Б; б) 3; в) 4; г) Д.

